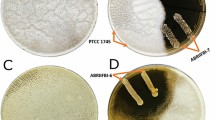

Abstract
The study aims to evaluate the cell-free supernatant (CFS) from Lactobacillus plantarum strain MYS44 against the growth and aflatoxin production by Aspergillus parasiticus MTCC 411. Standard in vitro techniques revealed the potential antifungal activity of CFS of LpMYS44. In poison food technique, it was observed that 6% CFS of LpMYS44 retarded maximum growth. The inhibition of A. parasiticus on peanuts confirmed the ability of CFS of LpMYS44 for biopreservation. Further, CFS of LpMYS44 was purified by chromatography and analyzed by GC-MS. The major antifungal compounds were oleic acid, octanoic acid, butanamide, and decanoic acid derivatives. Twofold concentrated 80 μL of CFS was found to be minimum inhibitory concentration (MIC) of CFS of LpMYS44. CFS of LpMYS44 suppressed the germination and growth of the spores of A. parasiticus. Microscopic observation showed that CFS of LpMYS44 severely affected the hyphal wall of A. parasiticus by the leakage of cytoplasmic content leading to complete destruction. Acidic condition is favorable for CFS of LpMYS44 activity. In poultry feed sample, CFS of LpMYS44 reduced the aflatoxin B1 content by 34.2%, reflecting its potentiality to use as detoxification agent. The multiple antifungal components in CFS of LpMYS44 exhibited antifungal properties against aflatoxigenic A. parasiticus resulted in causing overall morphological changes. Furthermore, we also observed the biopreservative ability of CFS of LpMYS44 against A. parasiticus and AFB1 reduction in for poultry feed. This study makes a contribution to using CFS of LpMYS44 and their applications in food and feed as pretreatment against aflatoxigenic A. parasiticus to reduce or eliminate AFB1 and maybe other aflatoxins, produced by other Aspergillus spp.
Similar content being viewed by others
Avoid common mistakes on your manuscript.
Introduction
Aflatoxins (AF) are mycotoxins that are produced by diverse Aspergillus species predominantly A. flavus and A. parasiticus. As secondary metabolites of these fungi, AF may contaminate a variety of food and feedstuffs, especially corn, peanuts, and cottonseed [1, 2]. The AF-contaminated food/feed causes deterioration, discoloration, and bad odors leading to severe complications in both livestock and humans, causing loss to the economy [3].
In several reports, researchers have attempted various methodologies to eliminate, inactivate, or reduce the presence of toxins in food and feedstuffs [4]. Some of the known physical and chemical strategies for detoxification of contaminated food and feed have been approved, but the use of certain chemical agents has disadvantages like nutritional value and sensory quality reduction in the processed food leading to deleterious effects on food and feed causing genotoxic and carcinogenicity [5, 6]. The use of mycotoxin binders is another way of trying to reduce the risk of mycotoxins in contaminated feed. However, these toxin binders possess a number of disadvantages with regard to impairment of mineral utilization, narrow range of binding efficacy, etc. [7].
Therefore, there is a need for exploring safe alternatives for minimizing AF contamination in food and feed. In this regard, Lactobacillus with potential antifungal property would be a better choice in place of chemical preservatives for reducing the AF content in food/feed [8], as these organisms have generally been recognized as safe. They exhibit antagonistic properties by secreting various compounds possessing antifungal activity [9]. Several antifungal compounds have been isolated from supernatants of Lactobacillus, including lactic and acetic acids [10, 11], caproic acid [12], phenyl lactic acid, 3-hydroxylated fatty acids, and cyclic dipeptides [13]. Sangmanee and Hongpattarakere [14] identified multiple antifungal compounds secreted by Lactobacillus plantarum and tested their role in reducing AF production by A. flavus. During olive storage, application of CFS of L. plantarum decreased the AFB1 levels by decreasing the quantity of molds [15]. Recently, Deepthi et al. [16] reported the potential attributes of antifungal metabolites isolated from L. plantarum against fumonisin-producing Fusarium proliferatum associated with poultry feed. However, there are limited reports on the antifungal activity of L. plantarum against aflatoxigenic A. parasiticus and its ability to reduce AF in poultry feed. Since A. parasiticus is the second most abundant producer of AF, there is a need to control the growth and contamination of aflatoxigenic A. parasiticus to overcome the problem of AF in food/feed.
In the present study, CFS from L. plantarum MYS44 (LpMYS44) was used to find out the antifungal activity, ability to inhibit the conidial germination of A. parasiticus. In addition, our study also characterized the antifungal components involved in the CFS of LpMYS44by GC-MS. Further, the preservative ability of CFS on peanuts was also tested, since Aspergillus and AF contamination is one of the major problems in the peanuts and poultry industry. The poultry feed is most vulnerable for the fungal contamination as well as mycotoxin problem, due to the use of peanuts as one of the major ingredients. Furthermore, AFB1 reduction potential in poultry feed was also studied.
Materials and Methods
Media and Microorganisms
Aflatoxigenic A. parasiticus MTCC 411 strain was obtained from the Microbial Type Culture Collection (MTCC), Institute of Microbial Technology, Chandigarh, India. De Man Rogosa Sharpe agar (MRS agar; HiMedia, Mumbai, India) for the growth of LpMYS44 and potato dextrose agar (PDA; HiMedia, India) for the growth of A. parasiticus was used. The conidia produced on the growth of A. parasiticus MTCC 411 were collected in a sterile container possessing Tween-20 (0.05%) (HiMedia, Mumbai, India). The count was adjusted to 106 conidia mL−1 using a hemocytometer.
Isolation and Characterization of LpMYS44
The strain LpMYS44 was isolated from the traditional fermented finger millet wine using conventional dilution and plating technique on MRS agar supplemented with 5% bromocresol purple (pH indicator). Further characterization of LpMYS44 was carried out by morphological, physiological, biochemical tests and also molecular identification by 16S rRNA gene sequencing using 27F and 1492R primers as per the protocol of Rao et al. [17] (data not shown). The culture was confirmed by standard microbiological tests which were maintained in glycerol stocks at -80 °C for further use.
Preparation of CFS of LpMYS44
From a stock culture, L. plantarum MYS44 was activated by two successive subcultures in MRS broth (HiMedia, Mumbai) at 37 °C for 24 h. The final culture was obtained by adding 30 mL of the last propagation culture to 1000 mL of MRS broth (HiMedia, Mumbai) and incubating at 37 °C for 24 h. The cell concentrations achieved were established between 9 and 9.9 log10 CFU mL−1. Then, cells were centrifuged at 5200g for 15 min at 4 °C. Further, the cell-free supernatant (CFS) obtained was twofold, threefold, fourfold, and sixfold concentrated at 70 °C in a Rotavapor followed by sterilization by filtration using 0.22-μm-pore-diameter membranes (HiMedia, Mumbai) and immediately used or stored at -20 °C until use within 1 month after their production.
Effect of CFS of MYS44 on Morphology of A. parasiticus Using Well Diffusion Assay
The antifungal activity of CFS of LpMYS44 was assessed by well diffusion assay. The CFS of LpMYS44 (100 μL) was poured into the wells of potato dextrose agar (HiMedia, Mumbai, India) plates swabbed with 10 μL of the conidial suspension (106 spores mL−1), allowed CFS of LpMYS44 to diffuse in the wells and incubated at 28 ± 2 °C for 5 to 7 days. The inhibitory portion of the mycelia near the zone of inhibition on the Petri plate was stacked with a cellophane tape and placed on the glass slide added with 2 to 3 drops of cotton blue stain. The morphological changes taking place in the mycelia by CFS of LpMYS44 were observed under a compound microscope (×100; Carl Zeiss, Germany).
Determination of MIC by Microdilution Method
The CFS of LpMYS44 was used to determine the MIC in a sterile 96-well microtiter plate. Ready-made soft agar (PDA, 100 μL) in the wells was inoculated with 10 μL of conidial suspension (106 spores mL−1) and twofold concentrated CFS of LpMYS44 (1 to 100 μL). Inoculated spore suspension in the PDA soft agar in the microtiter plate well without CFS and wells with PDA soft agar without spore suspension and CFS were served as positive and negative controls, respectively. The plate was observed for MIC, and the concentration at which fungal growth was retarded [18].
Conidial Germination Inhibition Assay
The inhibitory capability of CFS of LpMYS44 on conidial germination was studied in a 24-well microtiter plate as per the procedure of Deepthi et al. [16]. The reaction consisted of 200 μL of CFS of MYS44 and 100 μL of conidia (106 spores mL−1) mixed and made up to 1.0 mL using phosphate buffered saline (PBS). Control was 100 μL of A. parasiticus (106 spores mL−1) made up to 1.0 mL using PBS. The microtiter plate was incubated for 24 h at 28 ± 2 °C. Conidial germination at time intervals of 2, 4, 6, and 8 h was observed by staining the reacted sample with acridine orange (HiMedia, Mumbai, India) under a fluorescent microscope (Carl Zeiss, Germany). Germinated conidia were counted using hemocytometer. Conidia germination percent was calculated using the formula: [no. of conidia germinated / total conidia counted] × 100.
Effect of Different pH Treatments on CFS of LpMYS44 Activity
The inhibitory effect of CFS of LpMYS44 was assessed after treatment at pH levels of 3.0, 4.0, 5.0, and 7.0 ± 0.2. A. parasiticus spore suspension (106 spores mL−1) was dispensed to the media and the activity at each pH level was calculated as percent inhibition of A. parasiticus [19]. The MRS media with pH 3.0, pH 4.0, pH 5.0, and pH 7.0 devoid of CFS was served as the control for test of each pH. The media without pH treatment served as negative control. The inhibition percentage was calculated as follows:
I % = percent inhibition; C = growth diameter in control; T = growth diameter in pH-treated group.
Extraction and GC-MS Analysis of CFS of LpMYS44 for Potential Antifungal Metabolites
The CFS was collected from the freshly grown culture of LpMYS44 by centrifuging at 10,000 rpm for 30 min and extracted with ethyl acetate (1:3). Crude compound was purified using combined hexane/ethyl acetate solvent system and silica gel mini-column chromatography. The active fraction of the crude extract was initially rectified by thin-layer chromatography and analyzed using GC-MS at the sophisticated analytical instrumentation facility (IIT, Madras, India) with a TR-Wax MS column (length 30 m, film thickness 0.25 mm, ID 0.25 mm). The inlet temperature was 250 °C with the split ratio 10:1. Helium was used as the carrier gas at a constant flow rate of 1 mL/min. The active fraction of the compound was maintained at 40 °C for 2 min. The temperature was increased at the rate of 6 °C/min to 230 °C and held for 5 min. For MS detection, an electron ionization mode was used with ionization energy of 70 eV, ion source temperature of 245 °C, and scan mass range of 35–500 amu. The bioactive components were identified based on the comparison of their relative retention times and fragmentation patterns of mass spectra [18].
Quantification of AFB1 in Poultry Feed Treated with CFS of LpMYS44
Aspergillus and AF contamination is one of the major problems in the poultry industry. The poultry feed is most vulnerable for the fungal contamination as well as mycotoxin problem, due to the use of peanuts as one of the major ingredients. In view of this, we have selected both peanuts and poultry feed as a model system. Autoclaved poultry feed (10 g) was used in each of the following three groups: (1) positive control: feed inoculated with 50 μL (106 spores mL−1) of A. parasiticus spore suspension (poultry feed + A. parasiticus); (2) negative control: feed inoculated with 50 μL of MRS broth and 50 μL (106 spores mL−1) of A. parasiticus spore suspension (poultry feed + A. parasiticus + MRS broth); and (3) test: feed inoculated with 50 μL of CFS of LpMYS44and 50 μL (106 spores mL−1) of A. parasiticus spore suspension (poultry feed + A. parasiticus + CFS of LpMYS44). Inoculated plates were incubated at 28 ± 2 °C for 21 days. AFB1 determination and its quantification were done by a solvent extraction method, TLC (HiMedia, Mumbai, India) and UV spectrophotometer (Thermo Scientific) analysis. After 21 days of incubation, the inoculated feed samples from respective treatment were extracted with an equal volume (1:1) of chloroform. The organic phase obtained was pooled and concentrated using a rotary evaporator (Rotavapor, R300, India) at 350 bars and 50 °C. AFB1 in each treatment was detected on HPTLC plates (HiMedia, India) using the mobile phase chloroform:ethyl acetate (8:2) and observed under UV. Further, the fraction showing either blue or green band was pooled and concentrated as explained earlier. For further confirmation, the suspected AFB1 fraction was separated on HPTLC plates along with standard (AFB1 standard, procured from Sigma-Aldrich, India). The suspected AFB1 fraction was subjected to UV-visible spectra ranging from 200 to 600 nm. Spectra were analyzed for the presence of peak at 350 nm which confirms the presence of AFB1 in the sample. The concentration of AF in the samples was determined by using UV spectroscopy. A true analytical concentration of particular mycotoxin was measured as outlined in the Association of Official Analytical Chemists (AOAC) 16th Edition, Methods of Analysis. The absorbance at maximum wavelength was measured and compared to molar absorptivity and thus the concentration of AFB1 was determined as follows:
Percent Reduction (%) of AFB1 in the feed samples was calculated as,
T = AFB1concentration in treated sample; C = AFB1 concentration in positive control.
Biopreservative Efficacy of CFS of LpMYS44on Peanuts
The assay was carried out as per the procedure of Yang and Chang [8]. Peanuts (10 g) were soaked for 5 h in 100 mL distilled water, autoclaved and the cooked peanuts were soaked in the CFS of LpMYS44 at pH 3.5 ± 0.2 for 8 h at room temperature and transferred to sterile Petri dishes. Ten microliters of the conidial suspension (106 spores mL−1) was inoculated on each peanut seed. The assay was divided into four groups comprising of (1) control-inoculated with A. parasiticus and MRS broth, (2) peanuts treated with both CFS and A. parasiticus, (3) peanuts treated with CFS alone, and (4) a group with untreated peanuts and the mycelial growth was observed each day up to 6 days.
Statistical Analysis
Three independent replicates of each experiment were obtained. The results were expressed as significant differences of mean, standard deviation, and graphical representation using one-way ANOVA followed by Tukey’s post hoc test using GraphPad prism version 5.03.
Results
Antifungal Inhibitory Spectrum of CFS of LpMYS44
The CFS of LpMYS44 assayed for antifungal activity in well diffusion plates revealed that 100 μL of crude extract effectively controlled A. parasiticus growth, which is comparable to the standard nystatin (Fig. 1). In the MIC test, 80 μL of twofold CFS of LpMYS44 was considered as a minimal inhibitor based on the visible restriction of fungal growth (Fig. 2). Microscopic examination revealed that the mycelia were severely affected by CFS of LpMYS44 which is evident by the damage caused to the hyphal wall and subsequent leakage of cytoplasmic contents resulting in complete destruction (Fig. 3).
Effect of pH on Antifungal Activity of CFS of LpMYS44
The antifungal activity of CFS of LpMYS44 examined at different pH levels revealed that the inhibitory activity was reduced from 72 to 22% on neutralization, as compared to 30.65% for negative control (Fig. 4).
A. parasiticus Conidial Germination Inhibition Assay
The germination of conidia and mycelial growth were severely affected by CFS of LpMYS44. Based on the microscopic examination, there was a delay in germination of conidia in treated samples (A. parasiticus (106 spores/mL) + CFS of LpMYS44), and elongation of most of the germ tubes was hampered and did not grow (Fig. 5). However, 6.74% of conidial germination was observed at 6 h of incubation. The control group (A. parasiticus; 106 spores/mL) developed germ tube from the apical cells after 6 h of incubation with 44.2% conidial germination (Table 1). Due to the presence of bioactive metabolites in CFS of LpMYS44 in treated sample, the unfavorable environment caused disruption in conidial germination.
Spore germination inhibition of A. parasiticus by CFS of MYS44. (C) Control, A. parasiticus showing germtube initiation and formation at 6 and 8 h of incubation, respectively. (T) Treated, A. parasiticus treated with CFS of MYS44 showing retarded germination and germ tube formation. Images obtained by fluorescent microscopy at ×1000 magnification
Characterization of Potential Antifungal Metabolites
The GC-MS analysis of filter sterilized CFS of LpMYS44 in our study revealed 15 bioactive compounds among which 10 showed 100% base rate (Fig. 6A–B), which included butanamide, 2-hydroxy-N,3,3 trimethyl, octanoic acid, undecanoicacid-10-methyl-methyl ester, dodecanoic acid, tridecanoicacid-12-methyl-, methyl ester, tetradecanoic acid, hexadecanoicacid-methyl ester, n-hexadecanoic acid, 8-octadecanoic acid methyl ester and oleic acid (Table 2). However, docosanoic acid, methyl ester was found to be least base rate (51.8%). Oleic acid was the abundant antifungal component produced by LpMYS44.
Effect of CFS of MYS44 on AFB1 in Poultry Feed
Great efforts have been put in either to eliminate AFB1 completely or to reduce its content to significantly lower level in feed as the AFB1 is a potent source of health hazard to poultry and human. In the present study, poultry feed inoculated with A. parasiticus and CFS of LpMYS44 has shown to significantly reduce (37.5 μg/mL (34.2%)) AFB1 concentration compared to AFB1 concentration (57 μg/mL) in control sample (Fig. 7). The high reduction of AFB1 content in the CFS of LpMYS44-treated group may be due to the presence of antiaflatoxigenic metabolites produced by LpMYS44 during the growth and development.
Biopreservative Ability of CFS of LpMYS44 on Peanuts
As peanut forms the main constituent in animal feed and highly susceptible to Aspergillus contamination and AF production, edible peanuts were chosen as an experimental model to assess the preservative ability of Lactobacillus. In our current investigation, we found that the fungal growth of A. parasiticus was completely reduced in twofold-treated CFS group as compared to control after 6 days of incubation, suggesting that the CFS exhibited an inhibitory activity to control fungal growth on peanuts (Fig. 8). Controlling the growth of A. parasiticus on peanuts reduces the fungal contamination during storage and also facilitates to use of better raw materials.
Biopreservative efficacy of CFS of MYS44 on peanuts. Incubation after 6 days of incubation, peanuts treated with MRS broth and A. parasiticus in control showing presence of spores (a), complete inhibition on peanuts treated with CFS and A. parasiticus spores (b), CFS alone treated peanuts (c), untreated peanuts in the control group (d), respectively, showing no growth of A. parasiticus
Discussion
The antifungal activities of Lactobacillus strains have been reported by previous studies. Ilavenil et al. [20] observed a broad-spectrum antifungal property of Lactobacillus strains against Aspergillus fumigatus, Penicillium chrysogenum, Penicillium roqueforti, Botrytis elliptica, and Fusarium oxysporum. Thus, the present work reports on the efficacy of the CFS of LpMYS44 having multiple antifungal components that was able to demonstrate the antifungal activity and their ability to reduce or eliminate AFB1.
Similarly, metabolites of L. plantarum exhibited antifungal activity against bakery spoilage fungi such as, Gibberella moniliformis and A. fumigatus [21]. The microbial community composition along with environmental and growth conditions are the main factors for their antifungal activity [22]. According to Ilavenil et al. [20], the primary and secondary metabolites produced by Lactobacillus act as strong antagonistic agents and as microbial inhibitors. In the present study, we have used L. plantarum MYS44 isolated from finger millet (Eleusine coracana) wine. The morphological, physiological, biochemical, and molecular studies have confirmed its identification. Recently, Deepthi et al. [16] isolated multiple antifungal compounds from L. plantarum strain MYS6 which had inhibitory activity against fumonisin-producing F. proliferatum associated with poultry feed. The phylogenetic relationship between L. plantarum MYS44 and L. plantarum MYS6 has been represented in Fig. 9.
The inhibitory compounds were mainly organic acids comprising of lactic acid, oleic acid, octanoic acid, etc., which act as protective weapons against spoilage fungi. Though the isolates (LpMYS44 used in our study and LpMYS6 used by Deepthi et al. [16]) contribute to the antifungal activity against A. parasiticus and F. proliferatum, respectively, the isolate LpMYS44 shares some similarities and differences in the morphological, biochemical, and molecular identification features compared to isolate LpMYS6. For instance, the isolate LpMYS44 used in the present study exhibited similar morphological features like Gram positive, catalase negative, homo-fermentative, and positive for arginine hydrolysis. The divergent features include the isolate LpMYS44 that was from a different isolation source, able to ferment sorbitol, and unable to ferment arabinose, which are in contrast to the features of isolate LpMYS6. The phylogenetic analysis based on the 16S rDNA sequence showed that both isolates were in different nodes. In the present study, the secondary metabolites produced by LpMYS44 exhibited strong antifungal activity against A. parasiticus, which is the second major producer of AFB1.
The antifungal activity may not only be due to low pH in situ, but possibly, the secretion of antifungal organic metabolites also might have contributed. It is well known that Lactobacillus produces secondary metabolite acids like acetic and lactic or special acids. The ideal pH of the organic acids to penetrate the microbial cell is beneath their pKa values. The pKa values of common organic acids produced by Lactobacillus are below 5.0 [23]. Thus, in the present study, when the pH of CFS is above 5.0, the organic acids may not exhibit antifungal activity. Neutralization of CFS lowers the antifungal activity and this fact strongly suggests that the organic acids are responsible for the antifungal activity. Sangmanee and Hongpattarakere [14] reported that the activity of CFS of L. plantarum K35 was optimum at pH 4.0 but it rapidly decreased after neutralization, thereby supporting the present finding.
Several investigators have previously reported the interactions of CFS of Lactobacillus against the fungal conidial germination [24, 25]. In one study, the addition of concentrated CFS from L. reuteri R2 inhibited the germ tube formation and successive hyphal development in Trichophyton tonsurans [26]. Similarly, disruption and lysis of cell wall in Penicillium citrinum cell wall and reduction in hyphal wall branching were observed after treatment with brevicin SG1 produced by L. brevis SG1 [27]. Treatment of A. parasiticus MTCC 2796 with an unidentified antifungal compound from Pediococcus acidolactici LAB 5 produced undulating mycelial cell surface of mycelia and size reduction in conidial structures [28]. Our findings in morphological changes on conidial germination of A. parasiticus are consistent with the findings of Crowley et al. [25], who reported that the inhibition of spores, germ tubes, and hyphae of A. fumigatus Af293 was treated with unidentified antifungal compounds of L. plantarum [16].
In earlier studies, oleic acid has been shown to possess the potential inhibitory component against plant pathogenic fungi such as Rhizoctonia solani, Pythium ultimum, Pyrenophora avenae, and Crinipellis perniciosa [29]. In addition, Corcoran et al. [30] also demonstrated that the presence of oleic acid enhances the growth of Lactobacilli and their survival in gastric juice and Al-Naseri et al. [31] also reported that octanoic acid has a key role in lactose and galactose catabolic pathways of nonstarter lactic acid bacteria. Three antifungal substances such as cyclo-(Leu-Pro), 2,6-diphenyl-piperidine, and 5,10-diethoxy-2,3,7,8-tetrahydro-1 H, 6H-dipyroll [1,2-a; 1′, 2′-d] pyrazine were identified in some other Lactobacillus species but other than L. plantarum. They further established that octanoic acid is the synthetic acid name for the eight-carbon saturated fatty acid known by caprylic acid. In another study, Jiang et al. [32] reported the production of short chain diols such as dioxane derivatives as antifungal metabolites from Lactobacillus sp. On the other hand, Sjogren et al. [33] identified decanoic acid derivatives with antifungal properties in L. plantarum Mi LAB 14. As per these studies and several others, the identified antifungal compounds in the current study reflect the diversity and wide distribution among different strains of L. plantarum and different Lactobacillus sp. Our investigation also indicates that multiple bioactive compounds in CFS of LpMYS44 may have a significant contribution to the antifungal inhibitory potential against A. parasiticus, and furthermore, production of multiple antifungal compounds by LpMYS44 indicates a broad-spectrum inhibitory potential against aflatoxigenic A. parasiticus.
In support of our observation, Gourama et al. [34] also reported the presence of a metabolite that inhibited the accumulation of AF in cell-free extract of Lactobacillus. Karunaratne et al. [35] stated that the reduction in AF content was not due to the production of hydrogen peroxide or decrease in pH of the media but probably due to some specific antifungal metabolites produced by Lactobacillus. In addition, researchers have reported that the genus Lactobacillus are the better detoxifiers of AF than Pediococcus and Leuconostoc [36]. The detoxifying ability of Lactobacillus primarily depends on the activity of secondary metabolites that degrade toxins to less toxic or non-toxic forms. In a study by Sangmanee and Hongpattarakere [14], supernatant from L. plantarum was observed to reduce AF content by 36.77% in the growth medium. Similarly, Deepthi et al. [16] also reported the fumonisin detoxification ability of L. plantarum strain MYS6 using poultry feed as a model. There are very limited reports on the reduction of AFB1 by the supernatant of Lactobacillus using poultry feed model. Thus, the findings of our study indicate that the presence of multiple inhibitory components of CFS of LpMYS44 in poultry feed may hinder the growth and development of A. parasiticus and production of AFB1 by A. parasiticus. However, the detoxification mechanism reported here needs to be exploited further for practical application of CFS of LpMYS44 in poultry feeds.
The antagonistic properties of CFS of Lactobacillus against Aspergillus species have been reported in earlier studies. Kumar et al. [37] confirmed the inhibitory potential of Bacillus cereus against A. flavus and A. niger in the process of bakery food spoilage. In addition, Yang and Chang [8] reported the biopreservative efficacy of L. plantarum against A. flavus using soybean model and they found that the preservative property of L. plantarum was due to cyclo (Leu-Leu) present in the supernatant of cell culture. Rather et al. [11] who also studied L. plantarum-soya bean model reported that the fivefold concentrated CFS of L. plantarum YML007 completely inhibited the growth of A. niger. Hence, we also conclude as per the data we obtained in our study that the presence of inhibitory components in the CFS of LpMYS44 might have played a crucial role in controlling the A. parasiticus in peanuts, which forms an important component of poultry feed.
In conclusion, our present investigation showed that the multiple antifungal components with CFS of LpMYS44 exhibited antifungal properties against aflatoxigenic A. parasiticus. The antifungal property of these components resulted in causing overall morphological changes in A. parasiticus, destroyed the hyphal wall, and inhibited conidial germination. In addition, using chromatographic analysis, antifungal property of CFS of LpMYS44 is witnessed by AFB1 reduction in A. parasiticus. Furthermore, we also observed the biopreservative ability of CFS of LpMYS44 against A. parasiticus and AFB1 reduction in poultry feed. Thus, we conclude that the CFS of LpMYS44 may be further explored for their antifungal properties and their applications in food and feed as pretreatment against aflatoxigenic A. parasiticus to reduce or eliminate AFB1 and maybe other AF produced by other Aspergillus sp.
References
Yu J, Whitelaw C, NiermanWC BD, Cleveland TE (2004) Aspergillus flavus expressed sequence tags for identification of genes with putative roles in aflatoxin contamination of crops. FEMS Microbiol Lett 237:333–340
Rodrigues P, Venâncio A, Kozakiewicz Z, Lima N (2009) A polyphasic approach to the identification of aflatoxigenic and non-aflatoxigenic strains of Aspergillus Section Flavi isolated from Portuguese almonds. Int J Food Microbiol 129:187–193
Gerbaldo G, Barberis C, Pascual L, Dalcero A, Barberis L (2012) Antifungal activity of two Lactobacillus strains with potential probiotic properties. FEMS Microbiol Lett 332:27–33
Khanafari A, Soudi H, Miraboulfathi M (2007) Biocontrol of Aspergillus flavus and aflatoxin B1 production in corn. Iran J Environ Health Sci Eng 4:163–168
Guan D, Li P, Zhang Q, Zhang W, Zhang D, Jiang J (2011) An ultra-sensitive monoclonal antibody-based competitive enzyme immunoassay for aflatoxin M1 in milk and infant milk products. Food Chem 125:1359–1364
El-aziz ARMA, Mahmoud MA, Al-othman MR, Al-gahtani MF (2015) Use of selected essential oils to control aflatoxin contaminated stored cashew and detection of aflatoxin biosynthesis gene. Sci World J 1–13
Huwig A, Freimund S, Käppeli O, Dutler H (2001) Mycotoxin detoxication of animal feed by different adsorbents. Toxicol Lett 122(2):179–188
Yang EJ, Chang HC (2010) Purification of a new antifungal compound produced by Lactobacillus plantarum AF1 isolated from kimchi. Int J Food Microbiol 139:56–63
Wang H, Yan H, Shin J, Huang L, Zhang H, Qi W (2011) Activity against plant pathogenic fungi of Lactobacillus plantarum IMAU10014 isolated from Xinjiang koumiss in China. Ann Microbiol 61:879–885
Dalié DK, Deschamps AM, Atanasova-Penichon V, Richard-Forget F (2010) Potential of Pediococcus pentosaceus (L006) isolated from maize leaf to suppress fumonisin-producing fungal growth. J Food Prot 73(6):1129–1137
Ahmad Rather I, Seo BJ, Rejish Kumar VJ, Choi UH, Choi KH, Lim JH, Park YH (2013) Isolation and characterization of a proteinaceous antifungal compound from Lactobacillus plantarum YML007 and its application as a food preservative. Lett Appl Microbiol 57(1):69–76
Corsetti A, Gobbetti M, Rossi J, Damiani P (1998) Antimould activity of sourdough lactic acid bacteria: identification of a mixture of organic acids produced by Lactobacillus sanfrancisco CB1. Appl Microbiol Biotechnol 50(2):253–256
Strom K, Sjogren J, Broberg A, Schnurer J (2002) Lactobacillus plantarum MiLAB 393 produces the antifungal cyclic dipeptides cyclo (L-Phe-L-Pro) and cyclo (L-Phe-trans-4-OH-L-Pro) and 3-phenyllactic acid. Appl Environ Microbiol 68(9):4322–4327
Sangmanee P, Hongpattarakere T (2014) Inhibitory of multiple antifungal components produced by Lactobacillus plantarum K35 on growth, aflatoxin production and ultrastructure alterations of Aspergillus flavus and Aspergillus parasiticus. Food Control 40:224–233
Kachouri F, Ksontini H, Hamdi M (2014) Removal of aflatoxin B1 and inhibition of Aspergillusflavus growth by the use of Lactobacillus plantarum on olives. J Food Prot 77:1760–1767
Deepthi BV, Rao KP, Chennapa G, Naik MK, Chandrashekara KT, Sreenivasa MY (2016) Antifungal attributes of Lactobacillus plantarum MYS6 against fumonisin producing Fusarium proliferatum associated with poultry feeds. PloS One 11(6):e0155122
Poornachandra Rao K, Chennappa G, Suraj U, Nagaraja H, Charith Raj AP, Sreenivasa MY (2015) Probiotic potential of Lactobacillus strains isolated from sorghum-based traditional fermented food. Probiotics Antimicrob Proteins 7(2):146–156
Gerez CL, Torres MJ, Font de Valdez G, Rollán G (2013) Control of spoilage fungi by lactic acid bacteria. Biol Control 64:231–237
Wang H, Yan Y, Wang J, Zhang H, Qi W (2012) Production and characterization of antifungal compounds produced by Lactobacillus plantarum IMAU10014. PLoS One 7:e29452
Ilavenil S, Park HS, Vijayakumar M, Valan Arasu M, Kim DH, Ravikumar S, Choi KC (2015) Probiotic potential of Lactobacillus strains with antifungal activity isolated from animal manure. Sci World J
Arasu MV, Kim DH, Kim PI, Jung MW, Ilavenil S, Jane M, Choi KC (2014) In vitro antifungal, probiotic and antioxidant properties of novel Lactobacillus plantarum K46 isolated from fermented sesame leaf. Ann Microbiol 64(3):1333–1346
Schillinger U, Villarreal JV (2010) Inhibition of Penicillium nordicumin MRS medium by lactic acid bacteria isolated from foods. Food Control 21(2):107–111
De Muynck C, Leroy AI, De Maeseneire S, Arnaut F, Soetaert W, Vandamme EJ (2004) Potential of selected lactic acid bacteria to produce food compatible antifungal metabolites. Microbiol Res 159(4):339–346
Mauch A, Dal Bello F, Coffey A, Arendt EK (2010) The use of Lactobacillus brevis PS1 to in vitro inhibit the outgrowth of Fusarium culmorum and other common Fusarium species found on barley. Int J Food Microbiol 141(1):116–121
Crowley S, Mahony J, van Sinderen D (2013) Current perspectives on antifungal lactic acid bacteria as natural bio-preservatives. Trends Food Sci Technol 33(2):93–109
Guo J, Mauch A, Galle S, Murphy P, Arendt EK, Coffey A (2011) Inhibition of growth of Trichophyton tonsurans by Lactobacillus reuteri. J Appl Microbiol 111(2):474–483
Adebayo CO, Aderiye BI (2011) Suspected mode of antimycotic action of brevicin SG1 against Candida albicans and Penicillium citrinum. Food Control 22(12):1814–1820
Mandal V, Sen SK, Mandal NC (2013) Production and partial characterization of an inducer-dependent novel antifungal compound(s) by Pediococcus acidilactici LAB 5. J Sci Food Agric 93(10):2445–2453
Walters D, Raynor L, Mitchell A, Walker R, Walker K (2004) Antifungal activities of four fatty acids against plant pathogenic fungi. Mycopathologia 157:87–90
Corcoran BM, Stanton C, Fitzgerald GF, Ross RP (2007) Growth of probiotic Lactobacilli in the presence of oleic acid enhances subsequent survival in gastric juice. Microbiology 153:291–299
Al-Naseri A, Bowman JP, Wilson R, Nilsson RE, Britz ML (2013) Impact of lactose starvation on the physiology of Lactobacillus casei GCRL163 in the presence or absence of tween 80. J Proteome Res 12:5313–5322
Jiang Y, Liu W, Zou H, Cheng T, Tian N, Xian M (2014) Microbial production of short-chain diols. Microb Cell Factories 13(1):165
Sjogren J, Magnusson J, Broberg A, Schnürer J, Kenne L (2003) Antifungal 3-hydroxy fatty acids from Lactobacillus plantarum MiLAB 14. Appl Environ Microbiol 69(12):7554–7557
Gourama H, Bullerman LB (1995) Antimycotic and antiaflatoxigenic effect of lactic acid bacteria: a review. J Food Prot 58(11):1275–1280
Karunaratne A, WezenbergE BLB (1990) Inhibition of mold growth and aflatoxin production by Lactobacillus sp. J Food Prot 53(3):230–236
Zinedine A, Faid M, Benlemlih M (2005) In vitro reduction of aflatoxin B1 by strains of lactic acid bacteria isolated from Moroccan sourdough bread. Int J Agric Biol 7:67–70
Kumar SN, Sreekala SR, Chandrasekaran D, Nambisan B, Anto RJ (2014) Biocontrol of Aspergillus species on peanut kernels by antifungal diketopiperazine producing Bacillus cereus associated with entomopathogenic nematode. PLoS One 9(8):e106041
Acknowledgments
We thank the Central Instrumentation Facility, Institute of Excellence (IOE), University of Mysore for providing timely assistance for fluorescent microscopy. We also thank the SERB (Science and Engineering Research Board), India (No. EEQ/2016/000273; dated 23/02/2017) for their valuable support.
Author information
Authors and Affiliations
Corresponding author
Ethics declarations
Conflict of Interest
The authors declare that there is no conflict of interest.
Rights and permissions
About this article
Cite this article
Poornachandra Rao, K., Deepthi, B.V., Rakesh, S. et al. Antiaflatoxigenic Potential of Cell-Free Supernatant from Lactobacillus plantarum MYS44 Against Aspergillus parasiticus . Probiotics & Antimicro. Prot. 11, 55–64 (2019). https://doi.org/10.1007/s12602-017-9338-y
Published:
Issue Date:
DOI: https://doi.org/10.1007/s12602-017-9338-y